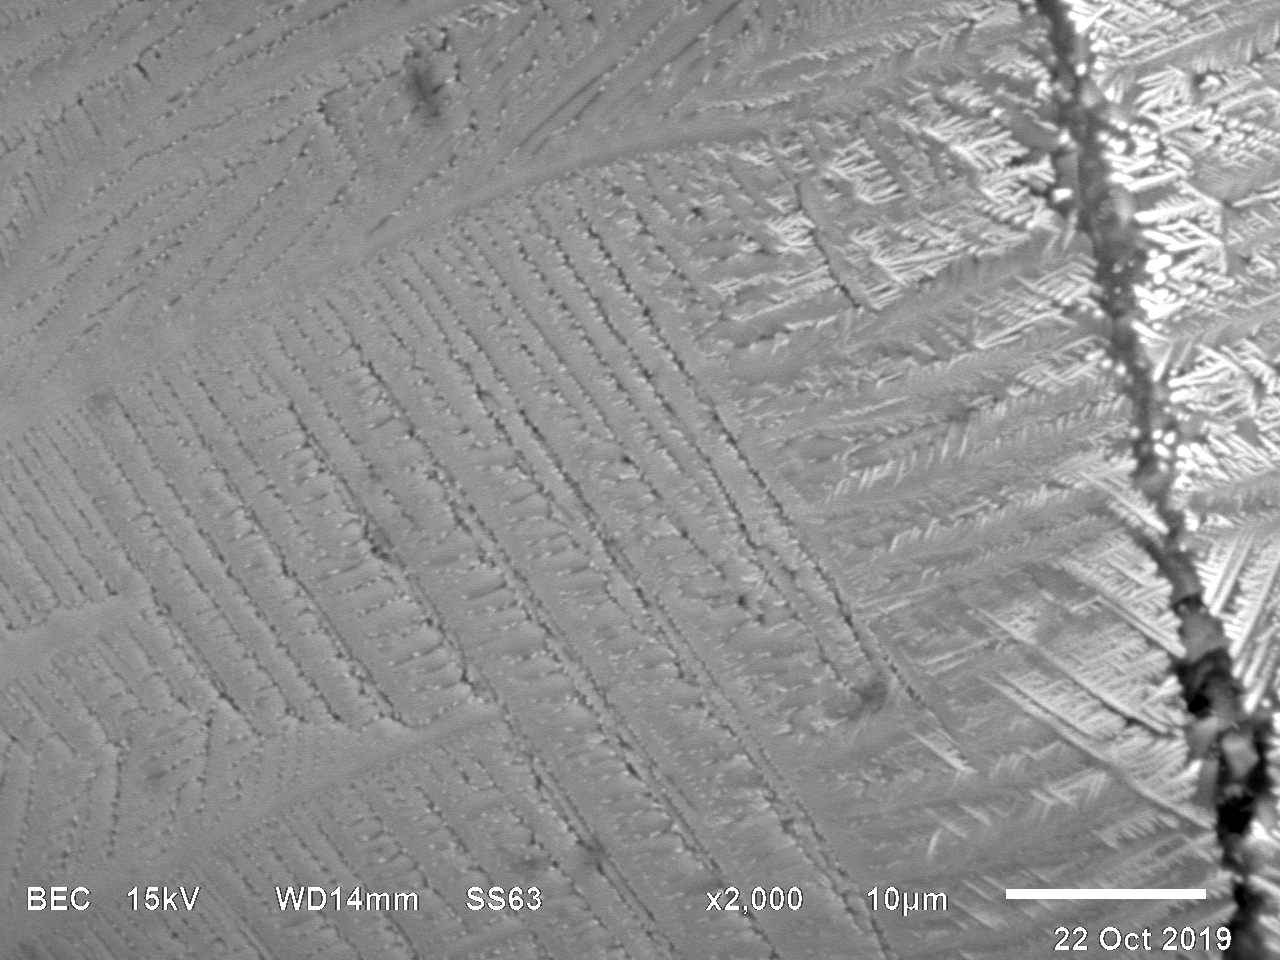
THMM310 – Bild 3

THMM310
Classification: Cryptocrystalline (CC), microcrystalline (MC)
Size: 120 x 145 µm | Shape: roundish | Colour: grey/black
Crystalline structure: submicron crystallites, oriented crystals
Metal differentiation: (Fe/Ni bead)
Magnetite: dendrites
Locality: site #51 | rooftop | N 52.470278, E 13.366278 | Terrestrial age: 0-16 a